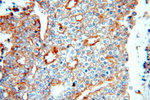
IGFBP2 Antibody in Immunohistochemistry (Paraffin) (IHC (P))

Search
Proteintech
IGFBP2 Polyclonal Antibody
{{$productOrderCtrl.translations['antibody.pdp.commerceCard.promotion.promotions']}}
{{$productOrderCtrl.translations['antibody.pdp.commerceCard.promotion.viewpromo']}}
{{$productOrderCtrl.translations['antibody.pdp.commerceCard.promotion.promocode']}}: {{promo.promoCode}} {{promo.promoTitle}} {{promo.promoDescription}}. {{$productOrderCtrl.translations['antibody.pdp.commerceCard.promotion.learnmore']}}
产品信息
15699-1-AP
种属反应
宿主/亚型
分类
类型
抗原
偶联物
形式
浓度
规格
纯化类型
保存液
内含物
保存条件
运输条件
产品详细信息
Immunogen sequence: MPCAELVRE PGCGCCSVCA RLEGEACGVY TPRCGQGLRC YPHPGSELPL QALVMGEGTC EKRRDAEYGA SPEQVADNGD DHSEGGLVEN HVDSTMNMLG GGGSAGRKPL KSGMKELAVF REKVTEQHRQ MGKGGKHHLG LEEPKKLRPP PARTPCQQEL DQVLERISTM RLPDERGPLE HLYSLHIPNC DKHGLYNLKQ CKMSLNGQRG ECWCVNPNTG KLIQGAPTIR GDPECHLFYN EQQEARGVHT QRMQ (76-328 aa encoded by BC004312)
靶标信息
IGFBP2 (insulin-like growth factor binding protein 2) is a member of the ISGBP family which bind various IGFs. IGFBP2 is overexpressed in a wide spectrum of cancers, including glioma, prostate cancer, synovial sarcoma, neuroblastoma, colon cancer, adrenocortical cancer, lung cancer, Wilms' tumor, and hepatoblastoma. The overexpression of IGFBP2 also correlates with the aggressiveness of some tumors. IGFBP2 activates the expression of matrix metalloprotease 2, which contributes to cell invasiveness.
仅用于科研。不用于诊断过程。未经明确授权不得转售。
篇参考文献 (0)
生物信息学
蛋白别名: IBP-2; IGF binding protein 2; IGF-binding protein 2; IGFBP; Insulin like growth factor binding protein; insulin-like growth factor binding protein 2; insulin-like growth factor binding protein 2, 36kDa; Insulin-like growth factor-binding protein 2; OTTHUMP00000207753; unnamed protein product
基因别名: BP2; IBP2; IGF-BP53; IGFBP2
UniProt ID: (Human) P18065
Entrez Gene ID: (Human) 3485